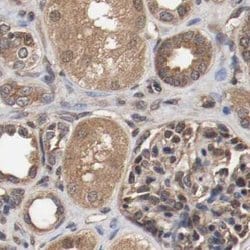
Invitrogen AFG3L2 Polyclonal Antibody 100 &mu;L; Unconjugated:Antibodies,

missing translation for 'onlineSavingsMsg'
Learn More
Learn More
Invitrogen™ AFG3L2 Polyclonal Antibody


Rabbit Polyclonal Antibody
Brand: Invitrogen™ PA552080
This item is not returnable.
View return policy
Description
Immunogen sequence: KTLLAKATAG EANVPFITVS GSEFLEMFVG VGPARVRDLF ALARKNAPCI LFIDEIDAVG RKRGRGNFGG QSEQENTLNQ LLVEMDGFNT TTNVVILAGT NRPDILDPAL LRPGRFDRQI FIGPPDIKGR ASIFKVHLRP LK Highest antigen sequence identity to the following orthologs: Mouse - 100%, Rat - 100%.
AFG3L2 is a protein localized in mitochondria and closely related to paraplegin. The paraplegin gene is responsible for an autosomal recessive form of hereditary spastic paraplegia. AFG3L2 gene is a candidate gene for other hereditary spastic paraplegias or neurodegenerative disorders. This gene encodes a protein localized in mitochondria and closely related to paraplegin. The paraplegin gene is responsible for an autosomal recessive form of hereditary spastic paraplegia. This gene is a candidate gene for other hereditary spastic paraplegias or neurodegenerative disorders.
Specifications
| AFG3L2 | |
| Polyclonal | |
| Unconjugated | |
| AFG3L2 | |
| 2310036I02Rik; AFG3 ATPase family gene 3-like 2; AFG3 ATPase family member 3-like 2; AFG3 like AAA ATPase 2; AFG3 like matrix AAA peptidase subunit 2; AFG3(ATPase family gene 3)-like 2; AFG3L2; AFG3-like AAA ATPase 2; AFG3-like protein 2; AFG3-like protein 2 (Paraplegin-like protein); ATPase family gene 3, yeast; AW260507; Emv66; FLJ25993; par; paraplegin-like protein; SCA28; si:ch211-12e1.4; similar to AFG3-like protein 2 (Paraplegin-like protein); SPAX5 | |
| Rabbit | |
| Antigen affinity chromatography | |
| RUO | |
| 10939 | |
| Store at 4°C short term. For long term storage, store at -20°C, avoiding freeze/thaw cycles. | |
| Liquid |
| Immunohistochemistry (Paraffin), Immunocytochemistry | |
| 0.1 mg/mL | |
| PBS with 40% glycerol and 0.02% sodium azide; pH 7.2 | |
| Q9Y4W6 | |
| AFG3L2 | |
| Recombinant protein corresponding to Human AFG3L2. Recombinant protein control fragment (Product #RP-102420). | |
| 100 μL | |
| Primary | |
| Human | |
| Antibody | |
| IgG |
Product Content Correction
Your input is important to us. Please complete this form to provide feedback related to the content on this product.
Product Title
Spot an opportunity for improvement?Share a Content Correction